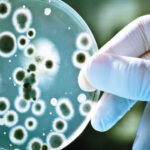

What is Intestinal Syndrome (IBS)? Symptoms: bowel syndrome is a condition also commonly called irritable bowel syndrome (IBS). This syndrome describes a specific problem in the digestive system and often includes symptoms such as abdominal pain, bloating, gas, constipation and diarrhea. Irritable bowel syndrome is not a disease, but a syndrome that describes certain symptoms. Although the exact cause of IBS is unknown, the interaction of several factors may play a role. Here are more details about bowel syndrome:

Irritable Bowel Syndrome (IBS): An In-Depth Overview
1. Definition and General Overview: Irritable Bowel Syndrome (IBS) is a functional gastrointestinal disorder characterized by a cluster of symptoms, including abdominal pain, bloating, gas, constipation, and diarrhea. IBS is a chronic condition with recurring episodes, and it does not cause any structural damage to the intestines.
2. Symptoms:
- Abdominal Pain and Discomfort: Cramp-like pain often felt in the lower abdomen.
- Bloating and Gas: Sensation of bloating due to accumulated gas in the intestines.
- Altered Bowel Habits: Fluctuating between constipation, diarrhea, or a combination of both.
- Mucus in Stool: Presence of mucus in the stool.
3. Causes and Risk Factors:
- Advertisement -
- Intestinal Motility Issues: Abnormalities in the contractions of the intestinal muscles.
- Nervous System Problems: Stress and issues related to the nervous system.
- Changes in Intestinal Microbiota: Imbalances in the gut microbiota.
- Genetic Factors: Increased risk in individuals with a family history of IBS.
4. Diagnosis:
- Symptoms and Medical History: Evaluation of the patient’s symptoms and medical history.
- Physical Examination: Examination of the abdomen and assessment of other physical signs.
- Laboratory Tests: Blood tests, stool tests, and sometimes imaging studies.
5. Treatment and Management:
- Dietary Modifications: Avoidance of specific foods or adherence to diets like the FODMAP diet; increasing fiber intake.
- Medications: Use of medications such as antispasmodics, probiotics, and laxatives to alleviate symptoms.
- Stress Management: Techniques like yoga, meditation, and relaxation methods to reduce stress.
6. Lifestyle Changes:
- Exercise: Regular physical activity to enhance intestinal motility.
- Hydration: Adequate water intake is crucial for intestinal health.
7. Prognosis:
- IBS is typically a lifelong condition, but symptoms can be managed effectively.
Conclusion:
Irritable Bowel Syndrome is a multifaceted condition, and its management involves a personalized approach based on individual symptoms. Seeking consultation with a healthcare professional is crucial for an accurate diagnosis and the development of an effective treatment plan. Management strategies often focus on symptom relief and improving the overall quality of life for individuals with IBS.
Click for more information!